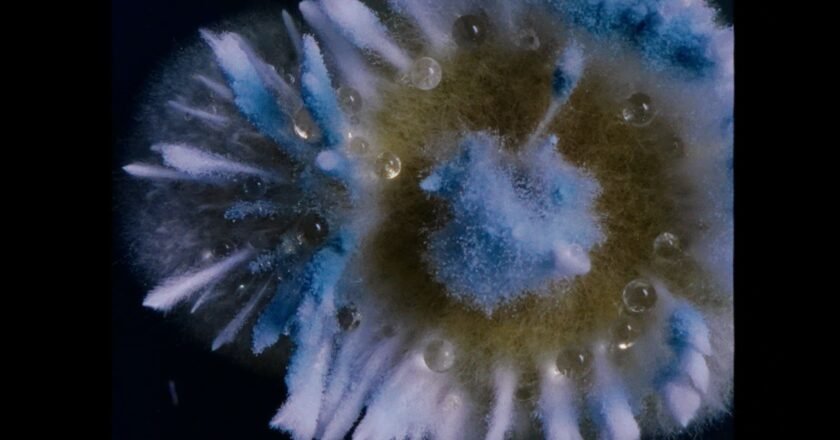

Stebuklingai mikroskopinius grybus įamžinęs mokslininkas P. Hickey: moksle visada slypi menas

Įspūdžiai po filmo „Dulkės, kaulai ir stebuklai“: kas yra didesnis stebuklas – meno kūriniai ar grybai?

Pristatyta meninė dokumentika „Dulkės, kaulai ir stebuklai“ – žiūrovai atras savo kino stebuklus

Lietuvių kūrėjai nufilmavo viduramžius menančią velykinę procesiją Ispanijoje: dvi savaites stebėjo vietinės brolijos gyvenimą

„Dulkės, kaulai ir stebuklai“ režisierė A. Žegulytė: kiekvienas suranda, kas jam amžina, o kas – laikina

„Kino pavasaryje“ pristatyta lietuviška premjera – tarptautiniuose festivaliuose apdovanotas filmas „Dulkės, kaulai ir stebuklai“

Amsterdamo dokumentinių filmų festivalyje Aistė Žegulytė ir jos grybų pasaulis pateko ant nugalėtojų pakylos – įteiktas apdovanojimas už geriausią režisūrą

Aistės Žegulytės filmo-kelionės į grybų pasaulį premjera – viename svarbiausių dokumentinio kino festivalių pasaulyje IDFA

Filmų programa „Taip toliau: GYVŪNO ŽVILGSNIU“ – nežmogiškąją būtį tyrinėjančių filmų premjeros, kino ir video meno klasika bei lietuviška dokumentika

Atidaryta pirmoji kino mokykla už Vilniaus ribų

Dokumentinio filmo „Apie žmones, žvėris ir daiktus“ kūrėjai už paramą atsidėkos barsuko iškamša

Pokalbis su Aiste Žegulyte apie žmogų tarp žmonių, žvėrių ir daiktų

Lietuviško kino dienų atidaryme – pirmojo išmaniojo filmo pasaulyje „Rūsys“ premjera



